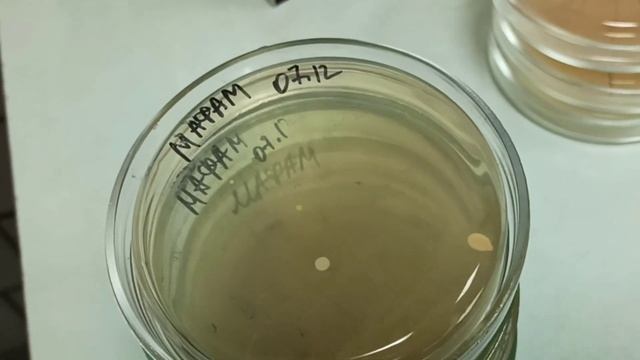
Бакпосев пищевых продуктов, общие краткие сведения смотреть онлайн

Автор: Мастерство в Деле Страница 4

Как нарисовать ПАНДУ карандашом. Портрет животного

Хороший способ использовать чёрствый батон или хлеб

Мастер класс.Накладные ресницы

Как поменять владельца группы в Одноклассниках. Как стать владельцем группы в социальных сетях?

ЧТО ПРИГОТОВИТЬ ИЗ БЫЧЬЕГО СЕРДЦЕ

Lyudmila Pakhomova & Alexander Gorshkov, Waltz (Short extract)

Окружающий мир 4 класс ч 2, тема урока Страницы истории XIX века, с 122 126, Шко

Мой шаблон параболы

Как давать отпор врагу. Алекс Кольер (1996).

Обзор ударного намордника

Как очищать территория в Minecraft?

Бюджетный отдых в Сочи 2021 за 12000 рублей! Цены, пляж и обзор номера

Урок 226 Часть 1 Протокол Оценки Искового Заявления Как Основа Для Формирования Других Процессуальн

Колёса прямо - как определить?

Как найти свои реквизиты карты на сайте сбербанк онлайн!1

Как сделать дубинку из бумаги

Подростковая преступность
Бакпосев пищевых продуктов, общие краткие сведения

Строю свое королевство с нуля в Kingdoms

Как открыть тушёнку топором

Как заводится BMW X5 дизель в мороз? Кузов F15

реверсивное движение саратовский мост

Заливка фундамента ЗИМОЙ! Как залить фундамент зимой/Дом который мы начали строить зимой Часть 1

Уроки рисования, Как нарисовать домик в лесу, Drawing lessons, how to draw a house in the woods
За каждым успешным каналом стоит личность, идея и сотни часов кропотливого труда. Если вы здесь, значит, автор «Мастерство в Деле» уже сумел зацепить ваше внимание своим уникальным стилем или подачей. А мы на RUVIDEO позаботились о том, чтобы вы могли изучить весь архив его работ в максимально комфортных условиях — без лишней суеты и преград.
Почему за работами канала «Мастерство в Деле» так интересно наблюдать? Всё просто: это честный контент, который находит отклик в сердцах зрителей. На нашем ресурсе вы можете смотреть онлайн все видео любимого автора бесплатно и в хорошем качестве. Нам важно, чтобы вы видели каждую деталь и слышали каждый нюанс, поэтому мы используем только стабильные плееры из открытых источников Rutube.
Следите за новинками канала, пересматривайте старые шедевры и открывайте для себя новые грани творчества «Мастерство в Деле». Мы постоянно обновляем ленту, чтобы у вас под рукой всегда были самые свежие выпуски. Никаких сложных регистраций — только вы и творчество, которое вдохновляет. Приятного вам путешествия по миру авторского контента на RUVIDEO!
Видео взято из открытых источников Rutube. Если вы правообладатель, обратитесь к первоисточнику.